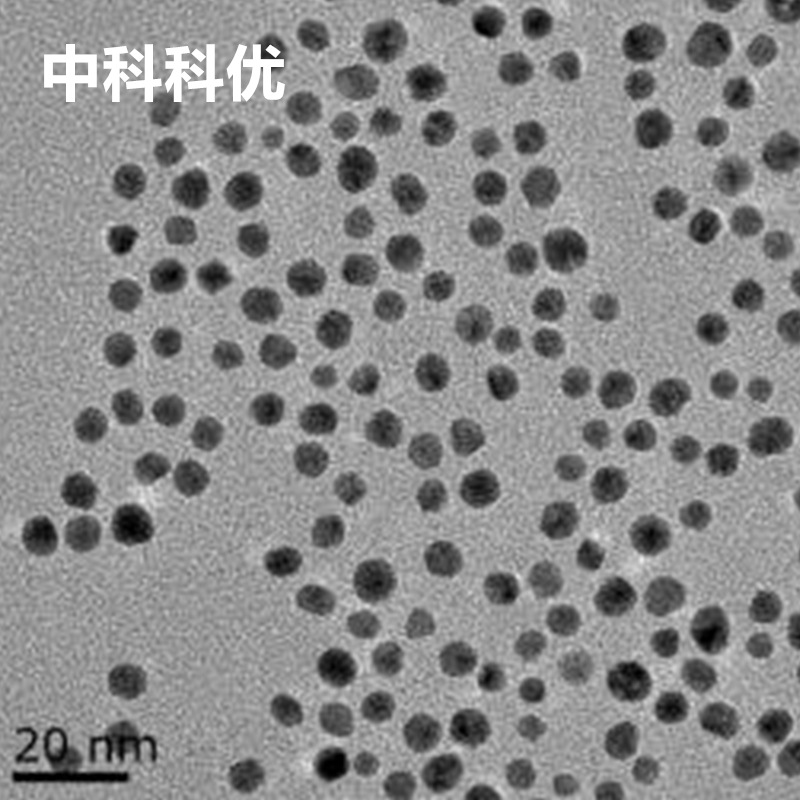
5nm水溶性金纳米颗粒1.jpg

金属纳米粒子

金属纳米颗粒可清除口腔细菌
图片尺寸401x268
贵金属在医疗保健应用潜力无限
图片尺寸527x353
各种金纳米颗粒gold nanoparticles
图片尺寸1347x896
球形金纳米颗粒
图片尺寸600x400
纳米镍铁合金颗粒高科高纯度3n6n高纯金属材料科研实验
图片尺寸500x500
分散很好地金属纳米颗粒是怎么做出来的如图
图片尺寸473x420
金纳米粒子的插图
图片尺寸700x490
走进贵金属纳米金的五彩缤纷
图片尺寸1000x499
黄金纳米粒子
图片尺寸400x291
金属镁粒
图片尺寸1024x768
【纳米】多面体 纳米 / 金属球 3d
图片尺寸1024x676
材料人评论 | 多孔金属纳米粒子,金属纳米材料未来的一种可能?
图片尺寸330x262
四氧化三铁纳米颗粒
图片尺寸300x225
5nm水溶性金纳米颗粒1.jpg
图片尺寸800x800
au-pd双金属纳米粒子,化学试剂厂家
图片尺寸400x400
如何才能得到截角八面体的金纳米颗粒的模型结构
图片尺寸600x570
西格玛材料科学提供全面的无机和金属纳米材料功能化纳米粒子和纳米
图片尺寸519x348
金纳米球(ctab包覆)
图片尺寸1000x1000
金纳米颗粒粉末
图片尺寸586x422
科研新进展利用金属纳米粒子研发定位成像药物载体
图片尺寸640x360